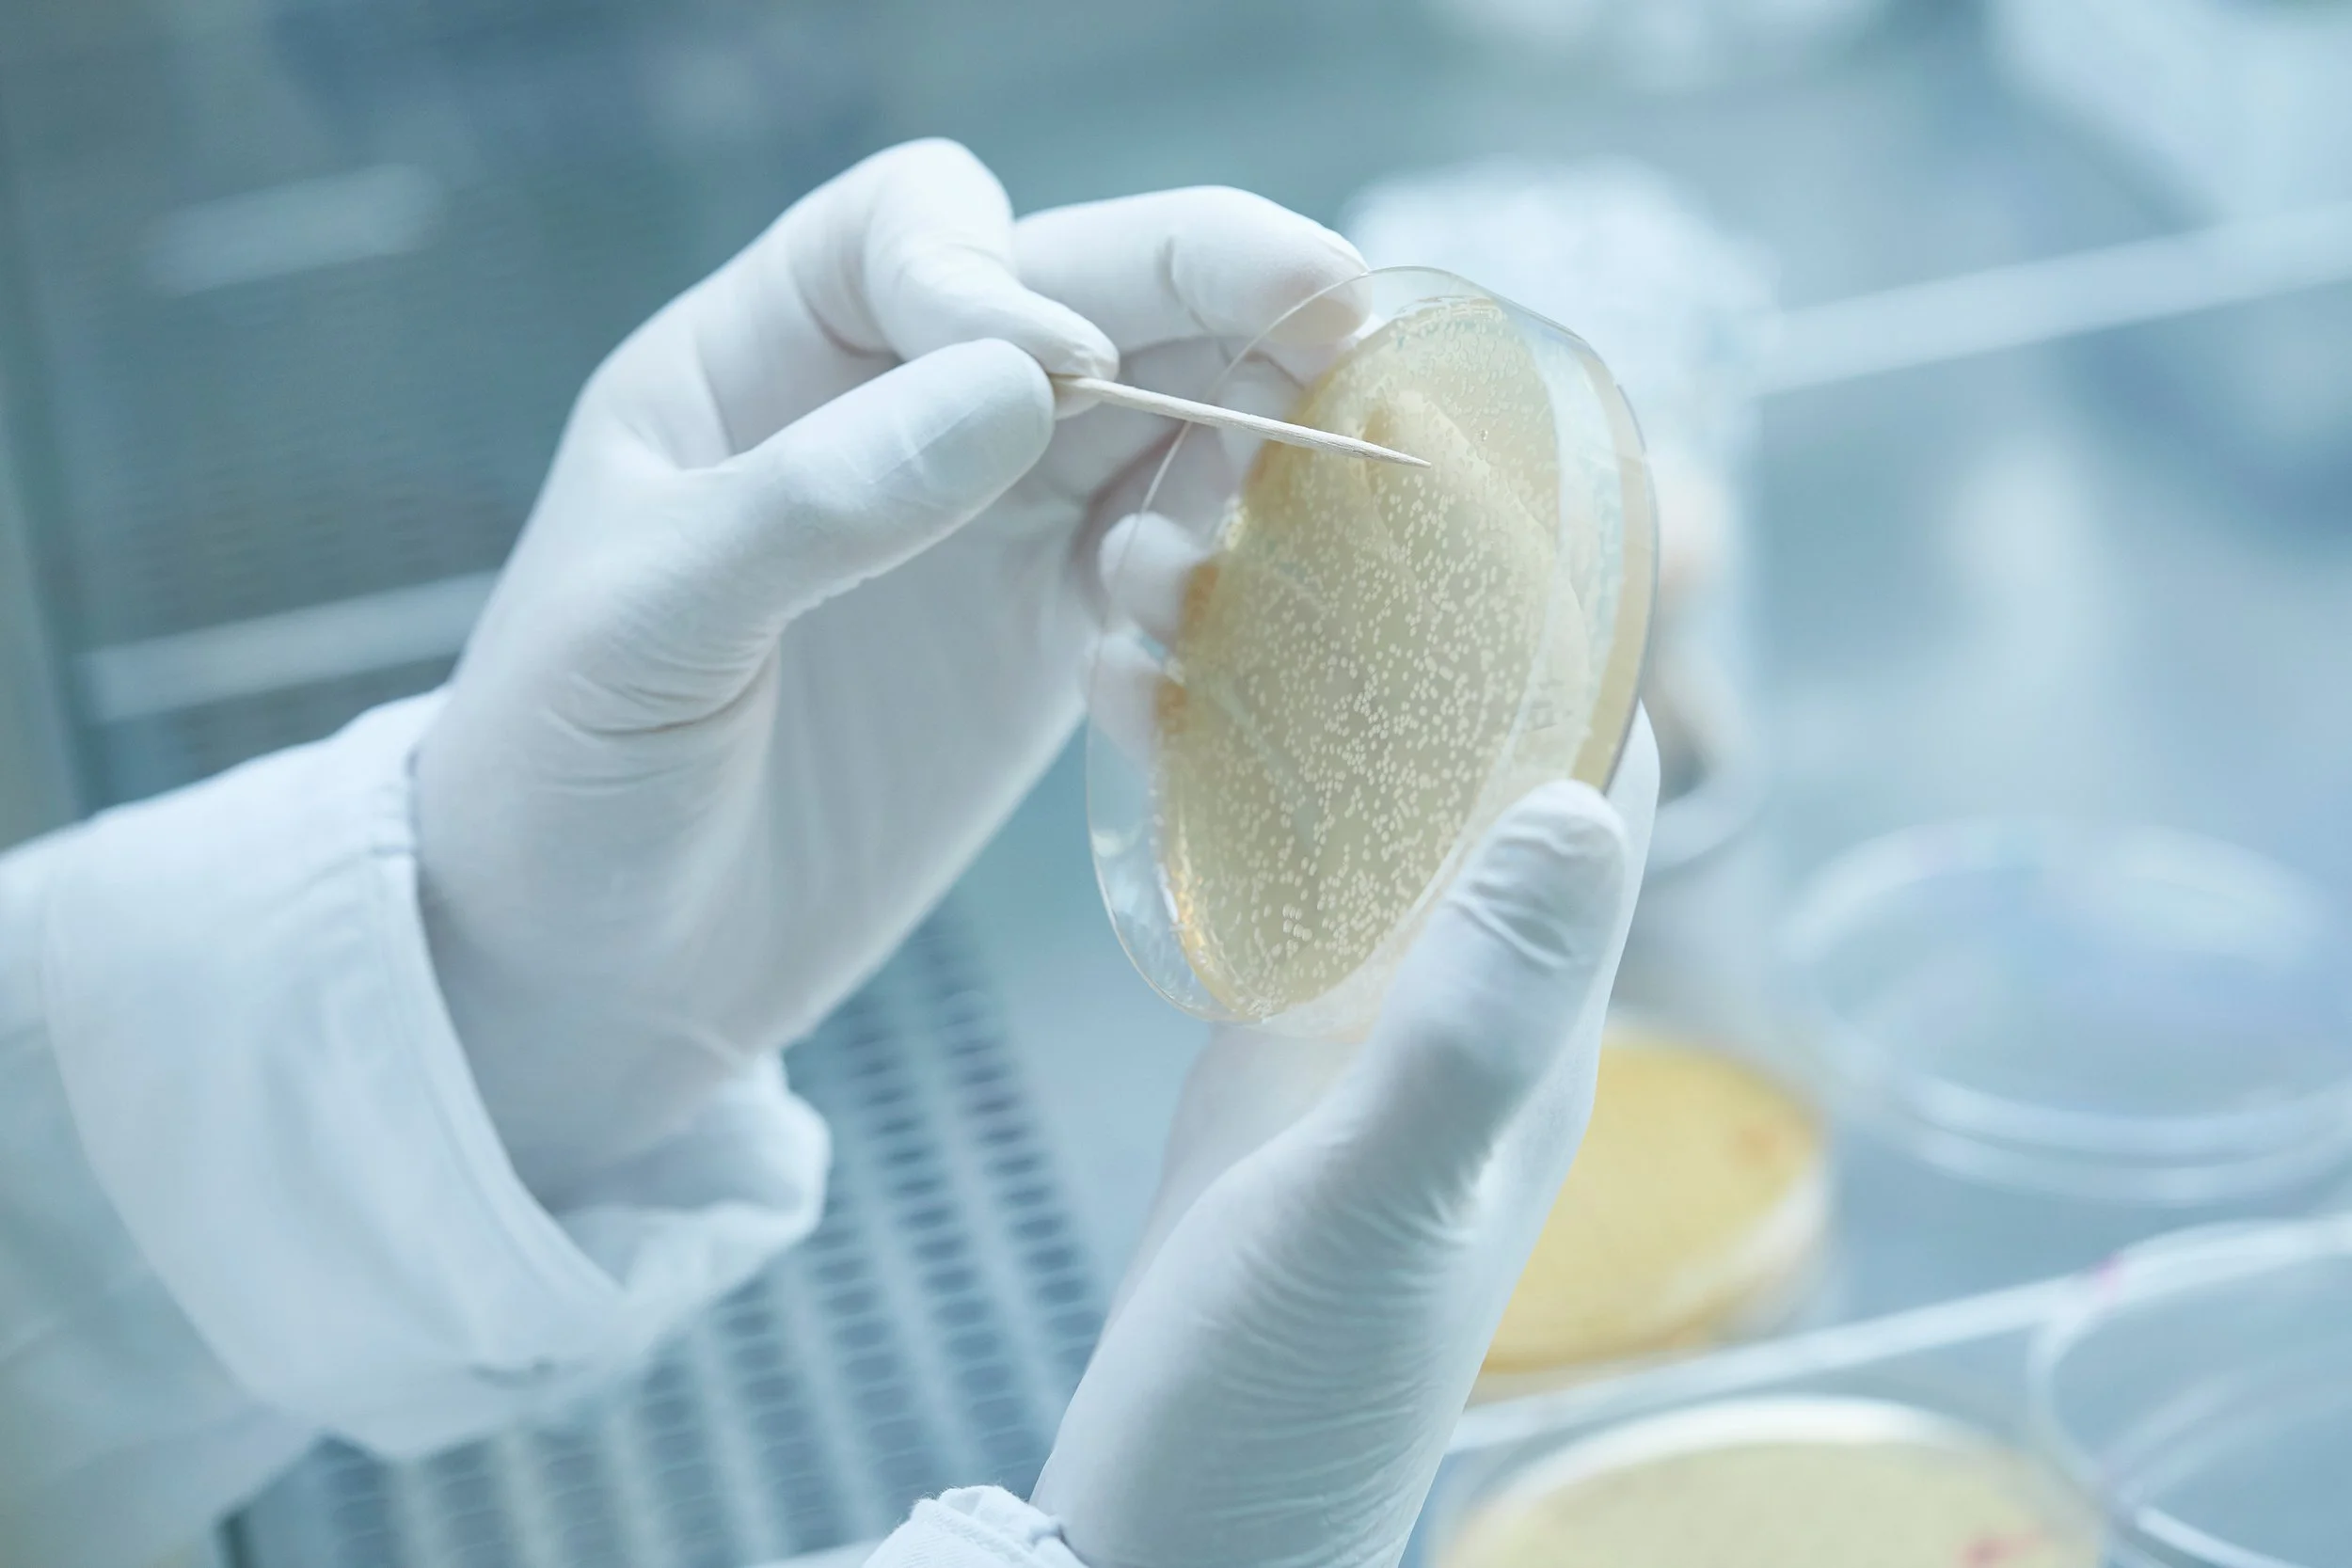
Limmatech Biologics

Kasernenareal – Heimatschutz
Step Zero
Restaurant Jurablick
Wassermann Architekten
LEM Holding
Modissa
Holzer Kobler Architekturen
Edition Unik
Aargauer Kuratorium
Friedhöfe Stadt Zürich - Heimatschutz
KSB - Kantonsspital Baden
FGZ – Familienheim Genossenschaft ZH
Limmatech Biologics
Stadtzürcher Sportbauten – Heimatschutz
Bookfactory
Via Maistra – Wassermann Architekten
Pro Senectute